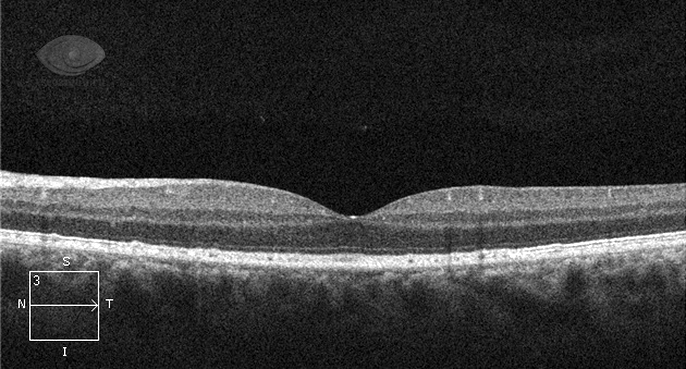
image

Макула — важная часть сетчатки, отвечающая за центральное зрение и восприятие деталей. Она критична для различения цветов, чтения и выполнения задач с высокой зрительной четкостью. В статье рассмотрим анатомию макулы, ее функции и распространенные заболевания, которые могут ухудшить зрение. Понимание этих аспектов поможет читателям заботиться о здоровье глаз и своевременно обращаться за медицинской помощью при первых признаках проблем.
Что такое макула?
Макула, или желтое пятно, — центральная часть сетчатки глаза, где сосредоточены фоторецепторы. Эта область обеспечивает четкое, яркое и цветное восприятие. Именно макула позволяет читать, распознавать лица и различать цвета.
Анатомически макула — округлая область сетчатки в задней части глаза диаметром около 5,5 мм. Внутри нее находится центральная часть — фовеа, диаметром 1,5 мм.
Макула имеет желтую окраску благодаря пигментам лютеину и зеаксантину.
Как центральная зона сетчатки, макула играет ключевую роль в зрении, обеспечивая четкость и восприятие цветов. Врачи подчеркивают важность поддержания здоровья этой области для сохранения остроты зрения. Заболевания макулы, такие как возрастная макулярная дегенерация и диабетическая макулопатия, могут вызвать серьезные проблемы со зрением. Специалисты рекомендуют регулярные обследования у офтальмолога, особенно людям старше 50 лет и тем, кто предрасположен к глазным заболеваниям. Также важен здоровый образ жизни, включая сбалансированное питание и защиту глаз от ультрафиолетового излучения. Своевременная диагностика и лечение заболеваний макулы могут значительно улучшить качество жизни и предотвратить потерю зрения.
Макула, как важная часть сетчатки, привлекает внимание специалистов в области офтальмологии. Эксперты подчеркивают, что здоровье макулы критически важно для сохранения центрального зрения, необходимого для выполнения повседневных задач, таких как чтение и вождение. Они отмечают, что возрастная макулярная дегенерация является одной из основных причин потери зрения у пожилых людей. Профилактика заболеваний макулы включает в себя правильное питание, богатое антиоксидантами, а также регулярные осмотры у офтальмолога. Врачи рекомендуют уделять внимание симптомам, таким как искажение зрения или появление темных пятен, так как ранняя диагностика может значительно улучшить прогноз. В целом, эксперты акцентируют внимание на важности комплексного подхода к сохранению здоровья макулы.
https://youtube.com/watch?v=-sPV6zaFPuQ
Палочки и колбочки
Фовеа является наиболее чувствительной частью сетчатки глаза и обеспечивает центральное зрение, т.е способность различать цвета и мелкие детали. За эту способность отвечают специальные клетки – колбочки, основная масса которых сконцентрирована именно в области желтого пятна. Палочки – другой вид светочувствительных клеток сетчатки, они располагаются на ее периферии и несут ответственность за периферическое зрение — сумеречное зрение, светоощущение и поле зрения. Высокая разрешающая способность макулы обусловлена анатомическими особенностями ее строения.
- Во-первых, она лишена сосудов, они здесь не проходят и не мешают свету попадать напрямую на фоторецепторы.
- Во-вторых, в макуле располагаются исключительно колбочки, оттесняющие все остальные слои сетчатки, таким образом, практически весь свет, проходящий через зрачок, фокусируется непосредственно на светочувствительных клетках – колбочках.
- В-третьих, колбочки имеют особую «прямую» связь с другими клетками. На одну колбочку приходится одна своя биполярная и ганглиозная клетки, что обуславливает четкую передачу светового раздражения дальше по зрительным волокнам нерва.
На периферии сетчатки, наоборот, на несколько палочек приходится одна биполярная, а на несколько биполярных – только одна ганглиозная клетка. Таким образом, периферия сетчатки способна обеспечить удивительную способность улавливать малейшие световые раздражения за счет суммации раздражений. Особенно хорошо это развито у животных.
| Симптом | Возможная причина (связанная с макулой) | Рекомендации |
|---|---|---|
| Снижение остроты зрения | Возрастная макулярная дегенерация (ВМД) | Регулярные осмотры у офтальмолога, здоровый образ жизни, лутеин и зеаксантин в рационе |
| Искажение прямых линий (метаморфопсия) | ВМД, макулярный отек | Немедленное обращение к офтальмологу |
| Центральное скотома (слепое пятно в центре поля зрения) | ВМД, макулярный разрыв | Немедленное обращение к офтальмологу |
| Помутнение зрения | Макулярный отек, диабетическая ретинопатия (с вовлечением макулы) | Контроль уровня сахара в крови (при диабете), лечение основного заболевания |
| Изменение цветовосприятия | ВМД, другие заболевания макулы | Обследование у офтальмолога для определения причины |
Интересные факты
Вот несколько интересных фактов о макуле:
-
Центр зрения: Макула — это небольшая область в сетчатке глаза, отвечающая за центральное зрение и восприятие деталей. Она содержит высокую концентрацию фоторецепторов, особенно колбочек, которые позволяют различать цвета и четко видеть объекты.
-
Возрастные изменения: С возрастом макула может подвергаться изменениям, что приводит к возрастной макулярной дегенерации (АМД) — одной из ведущих причин потери зрения у людей старше 50 лет. Это заболевание может значительно повлиять на качество жизни, так как затрудняет выполнение повседневных задач, таких как чтение и вождение.
-
Защита макулы: Антиоксиданты, такие как лютеин и зеаксантин, могут помочь защитить макулу от повреждений, вызванных свободными радикалами и ультрафиолетовым излучением. Эти вещества содержатся в зеленых листовых овощах, таких как шпинат и капуста, а также в некоторых фруктах, таких как киви и виноград.
https://youtube.com/watch?v=Bz97D9bmBLk
Лютеин и зеаксантин
Желтый оттенок макулы обусловлен наличием лютеина и зеаксантина, пигментов, содержащихся в оранжевых, желтых и зеленых овощах, таких как кукуруза, шпинат и цветная капуста. Эти вещества формируют пигмент желтого пятна в сетчатке и защищают фоторецепторы. Они являются мощными антиоксидантами и фильтрами синего света, предотвращая повреждение клеток сетчатки.
С возрастом уровень макулярного пигмента снижается, что может привести к повреждениям сетчатки и развитию заболеваний, таких как возрастная макулярная дегенерация (ВМД).
Макула — ключевая область сетчатки, отвечающая за центральное зрение и восприятие цветов. Многие отмечают, что здоровье макулы влияет на качество жизни. С возрастом возникают проблемы, такие как ВМД, что вызывает беспокойство. Люди делятся историями о том, как изменения в зрении затрагивают повседневные дела, от чтения до вождения. Некоторые подчеркивают важность регулярных осмотров у офтальмолога и сбалансированного питания для поддержания здоровья макулы. В социальных сетях обсуждают витамины и добавки, способствующие сохранению зрения. Обсуждения акцентируют внимание на важности осведомленности и профилактики, ведь здоровье глаз — залог активной жизни.
Симптомы при заболеваниях макулы
Основным симптомом заболеваний макулярной области является нарушение центрального зрения. Как правило, пациенты с макулярными заболеваниями замечают «что-то, закрывающее часть поля зрения в центре».
- Расстройства цветового зрения – снижение цветности, яркости, контрастности изображения.
- Искривления изображения или метаморфопсии – довольно частый признак при изменениях в макуле.
- Изменение размеров изображения, возможно как их увеличение, так и уменьшение, что связано изменением расстояния между колбочками.
https://youtube.com/watch?v=tSl0-hsjY2Y
Методы диагностики макулы
Для исследования макулярной зоны применяются различные диагностические методы:
- Офтальмоскопия с использованием специализированных линз и освещения.
- Оптическая когерентная томография позволяет получать изображения всех слоев макулярной области с высокой точностью.
- Флюоресцентная ангиография с контрастными веществами окрашивает сосудистую сеть сетчатки, что помогает выявлять заболевания макулярной области.
- Компьютерная периметрия обнаруживает выпадения в центральной части поля зрения – скотомы.
Лечение заболеваний макулы
Лечение заболеваний макулы является важной задачей в офтальмологии, так как макула отвечает за центральное зрение и восприятие деталей. Заболевания макулы могут привести к значительному ухудшению зрения и даже слепоте, поэтому ранняя диагностика и адекватное лечение имеют решающее значение.
Существует несколько основных заболеваний макулы, включая возрастную макулярную дегенерацию (ВМД), диабетическую макулопатию, макулярные отеки и макулярные разрывы. Каждое из этих состояний требует индивидуального подхода к лечению.
Возрастная макулярная дегенерация (ВМД) делится на сухую и влажную формы. Сухая форма, являющаяся более распространенной, обычно лечится с помощью витаминов и антиоксидантов, которые могут замедлить прогрессирование заболевания. Влажная форма требует более активного вмешательства, включая инъекции анти-VEGF препаратов, которые помогают уменьшить прорастание новых кровеносных сосудов и отек.
Диабетическая макулопатия возникает у пациентов с диабетом и требует контроля уровня сахара в крови. Лечение может включать лазерную терапию, которая помогает предотвратить дальнейшее ухудшение зрения, а также инъекции препаратов, направленных на уменьшение отека.
Макулярные отеки могут быть вызваны различными факторами, включая воспалительные процессы и травмы. Лечение может включать кортикостероиды, которые помогают уменьшить воспаление, а также инъекции анти-VEGF препаратов.
Макулярные разрывы часто требуют хирургического вмешательства, такого как витрэктомия, для восстановления целостности макулы. В некоторых случаях может потребоваться установка специальной газовой пузырьковой инъекции, чтобы помочь макуле восстановиться.
Важно отметить, что выбор метода лечения зависит от стадии заболевания, общего состояния здоровья пациента и наличия сопутствующих заболеваний. Регулярные осмотры у офтальмолога и соблюдение рекомендаций по лечению могут значительно улучшить прогноз и качество жизни пациентов с заболеваниями макулы.
Современные технологии, такие как оптическая когерентная томография (ОКТ), позволяют более точно диагностировать заболевания макулы и отслеживать их прогрессирование, что способствует более эффективному лечению.
Вопрос-ответ
Что такое макула и какую роль она играет в зрении?
Макула — это небольшая область в центре сетчатки глаза, отвечающая за остроту зрения и восприятие цветов. Она содержит высокую концентрацию фоторецепторов, что позволяет нам видеть детали и различать цвета в ярком свете.
Какие заболевания могут затрагивать макулу?
Наиболее распространенные заболевания, затрагивающие макулу, включают возрастную макулярную дегенерацию, диабетическую макулопатию и макулярные отслойки. Эти состояния могут привести к ухудшению центрального зрения и требуют своевременной диагностики и лечения.
Как можно защитить здоровье макулы?
Для защиты здоровья макулы рекомендуется соблюдать здоровый образ жизни: правильно питаться, включая в рацион продукты, богатые антиоксидантами (например, шпинат, морковь, рыба), избегать курения, контролировать уровень сахара в крови и регулярно проходить обследования у офтальмолога.
Советы
СОВЕТ №1
Регулярно проходите обследования у офтальмолога, особенно если у вас есть предрасположенность к заболеваниям сетчатки. Раннее выявление проблем с макулой может значительно улучшить прогноз и сохранить зрение.
СОВЕТ №2
Обратите внимание на свое питание. Включите в рацион продукты, богатые антиоксидантами, такие как шпинат, брокколи, морковь и рыба, содержащая омега-3 жирные кислоты. Эти вещества помогают поддерживать здоровье макулы.
СОВЕТ №3
Защищайте свои глаза от ультрафиолетового излучения, носите солнцезащитные очки с высоким уровнем защиты. Это поможет снизить риск повреждения макулы и других частей глаза.
СОВЕТ №4
Поддерживайте здоровый образ жизни: избегайте курения, контролируйте уровень сахара и холестерина в крови, а также занимайтесь физической активностью. Все это способствует общему здоровью глаз и снижает риск заболеваний макулы.